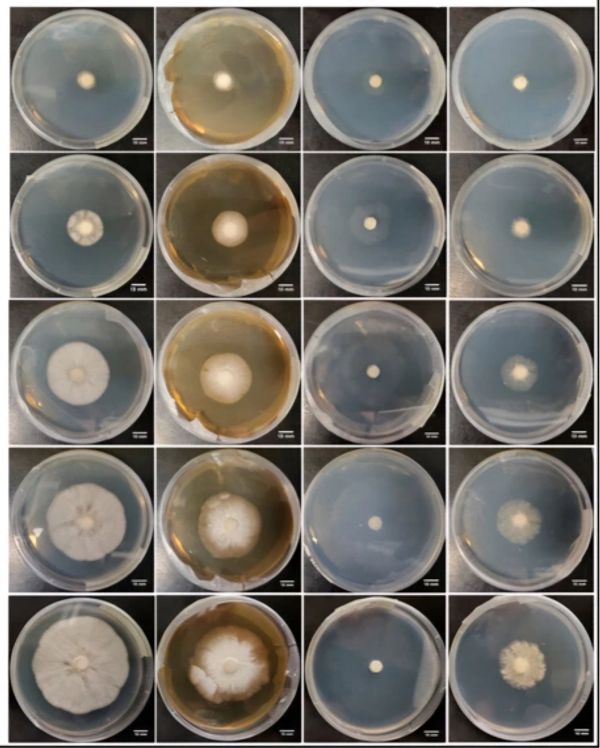

Reach out to us to discuss your research goals and how we can collaborate.
We strive to stay in communication with our clients. Have a question about our business, or want to see if we match your specific needs? Send us an e-mail. We're always happy to meet new customers!
We use cookies to analyze website traffic and optimize your website experience. By accepting our use of cookies, your data will be aggregated with all other user data.